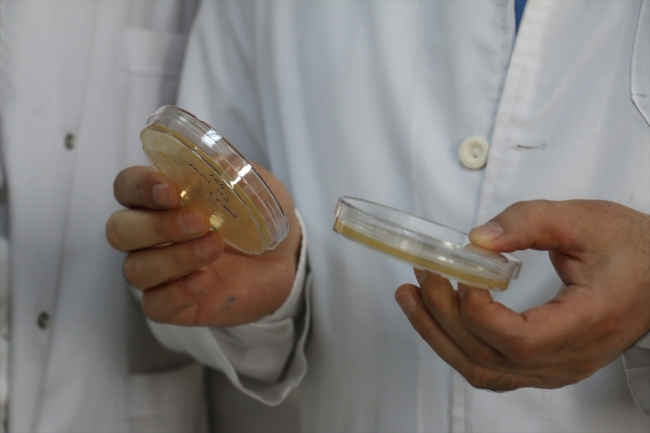
Erzurum'da yerli "nano-keratin" üretildi

Atatürk Üniversitesi Fen Fakültesi Öğretim Üyesi Prof. Dr. Esabi Başaran Kurbanoğlu ve ekibinin 25 yıllık çalışmasının ardından biyo-teknolojik teknikler kullanılarak üretilen yerli keratin için patent başvurusu yapıldı.

Atatürk Üniversitesi Rektörü Prof. Dr. Ömer Çomaklı, üniversite olarak bilgiyi toplumla buluşturan çalışmalara destek verdiklerini, Prof. Dr. Kurbanoğlu ve ekibi tarafından üretilen çalışmanın da bu yönde değerlendirilmesi gerektiğini belirtti.

Çomaklı, bilginin ürüne ve değere dönüşmesine önem verdiklerini ifade ederek, "Üniversite olarak amacımız, çalışmalarımızın Türkiye'nin ekonomisine ve büyümesine katkı sağlamasıdır. Bu tip çalışmalara hem destek veriyoruz hem teşvik ediyoruz hem de bu tür çalışmaların yapılabilmesi için gereken ortamları oluşturuyoruz. Arkadaşlarımıza bu çalışmalarından dolayı teşekkür ediyoruz" dedi.
"Türkiye'de bir ilk"
Prof. Dr. Kurbanoğlu ise ürettikleri keratin maddesinin, ileri boyutta bir nano özelliği taşıdığını belirterek, Türkiye'de bir ilke imza attıklarını savundu.
Çalışmaların 25 yıl önce başladığına değinen Kurbanoğlu, dünya literatüründe konuyla ilgili yayımlanmış bilimsel makalelerinin olduğunu vurguladı.

Çalışma süresince yurt dışında üretilen keratinleri incelediğini anlatan Kurbanoğlu, "2005 yılında keratini kullanılabilir bir forma soktuk. Nihayet bugün üretir noktaya geldik. Bu ürün 25 yıllık bir birikimin eseridir" dedi.
"Zararlı yan etkisi de yoktur"
Esabi Başaran Kurbanoğlu, yurt dışından ithal edilen keratinlerin kanserojen madde içerdiğini belirterek, yerli üretim keratinle ithal keratin arasındaki farkla ilgili şu bilgileri verdi:
"Ürettiğimiz keratinin ithal edilenlerden en temel farkı çok saf ve nano boyutta oluşudur. İthal edilene nazaran ürettiğimiz keratinin içerisinde herhangi bir toksit ya da katkı maddesi yoktur. Yerli üretimimiz olan keratinin kokusu da rengi de ithal edilenlerden farklıdır. Herhangi bir zararlı yan etkisi de yoktur."

Doğal ürünlerden toz halde elde edilip suda hemen çözülebilen ve raf ömrü uzun olan nano-keratinin, aynı zamanda yüksek kaliteli de olduğunu anlatan Kurbanoğlu, bu maddeden krem ve şampuan yapılarak etkili bir şekilde kullanılabileceğini söyledi.
Kaynak: AA